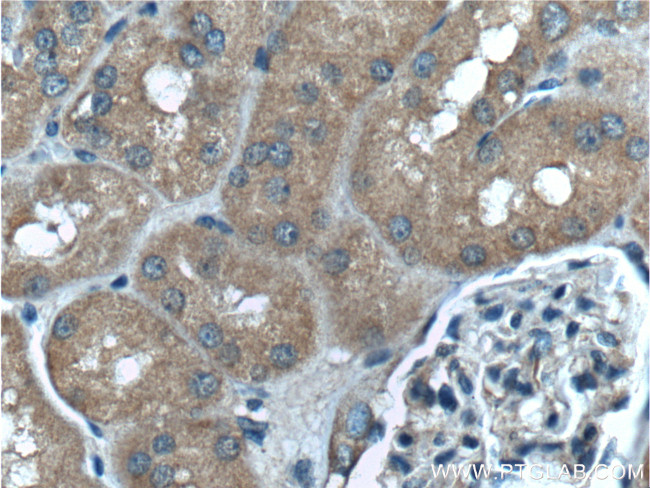
PLAA Antibody in Immunohistochemistry (Paraffin) (IHC (P))
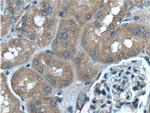
PLAA Antibody in Immunohistochemistry (Paraffin) (IHC (P))

Search
Proteintech
PLAA Monoclonal Antibody (5C10G9)
{{$productOrderCtrl.translations['antibody.pdp.commerceCard.promotion.promotions']}}
{{$productOrderCtrl.translations['antibody.pdp.commerceCard.promotion.viewpromo']}}
{{$productOrderCtrl.translations['antibody.pdp.commerceCard.promotion.promocode']}}: {{promo.promoCode}} {{promo.promoTitle}} {{promo.promoDescription}}. {{$productOrderCtrl.translations['antibody.pdp.commerceCard.promotion.learnmore']}}
产品信息
60244-1-IG
种属反应
宿主/亚型
分类
类型
克隆号
抗原
偶联物
形式
浓度
纯化类型
保存液
内含物
保存条件
运输条件
产品详细信息
Immunogen sequence: GAGRYVPGS ASMGTTMAGV DPFTGNSAYR SAASKTMNIY FPKKEAVTFD QANPTQILGK LKELNGTAPE EKKLTEDDLI LLEKILSLIC NSSSEKPTVQ QLQILWKAIN CPEDIVFPAL DILRLSIKHP SVNENFCNEK EGAQFSSHLI NLLNPKGKPA NQLLALRTFC NCFVGQAGQK LMMSQRESLM SHAIELKSGS NKNIHIALAT LALNYSVCFH KDHNIEGKAQ CLSLISTILE VVQDLEATFR LLVALGTLIS DDSNAVQLAK SLGVDSQIKK YSSVSEPAKV SECCRFILNL L (496-795 aa encoded by BC032551)
靶标信息
Phospholipase A-2-activating protein (PLAA), also named PLAP, can interact with ubiquitin and is involved in the maintenance of ubiquitin levels. PLAA contains multiple consensus domains including WD repeats, PFU domain and PUL domain. Although the function of PLAA remains unclear, ubiquitin binding of PLAA might be the central role that connects ubiquitination and degradation in ERAD. Recent finding revealed that PLAA served as a novel nociceptive mediator after incision, and its expression level is regulated by miR-203.
仅用于科研。不用于诊断过程。未经明确授权不得转售。
篇参考文献 (0)
生物信息学
蛋白别名: DOA1 homolog; Phospholipase A-2-activating protein; phospholipase A2-activating protein; PLA2P
基因别名: 2410007N06; AI536418; AU018445; AW208417; D4Ertd618e; DOA1; PLA2P; PLAA; PLAP; Ufd3
UniProt ID: (Human) Q9Y263, (Mouse) P27612, (Rat) P54319
Entrez Gene ID: (Human) 9373, (Mouse) 18786, (Rat) 116645